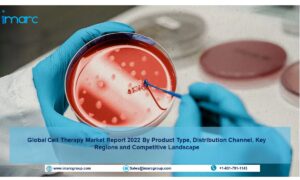

The latest research study „Cell Therapy Market: Global Industry Trends, Share, Size, Growth, Opportunity and Forecast 2022-2027“ by IMARC Group, finds that the global cell therapy market size reached US$ 9.17 Billion in 2021. Looking forward, IMARC Group expects the market to reach US$ 27.05 Billion by 2027, exhibiting a growth rate (CAGR) of 18.60% during 2022-2027.
Cell therapy (CT) represents the transplantation of human cells to repair or replace damaged tissues and cells. It comprises skeletal muscle and mesenchymal stem cells, hematopoietic stem cells (HSC), lymphocytes, and dendritic and pancreatic islet cells. Cell therapy improves the immune system of the body to fight cancer cells. It also assists in treating various conditions, such as urinary problems, damaged cartilage in joints, spinal cord injuries, autoimmune and infectious diseases, a weakened immune system, neurological disorders, etc. As a result, cell therapy finds extensive utilization in manufacturing regenerative medicines for developing and applying new treatments to heal tissues and organs and restoring functions lost, owing to disease, aging, and damage.
Request a Free PDF Sample for more detailed market insights: https://www.imarcgroup.com/cell-therapy-market/requestsample
Note: We are regularly tracking the direct effect of COVID-19 on the market, along with the indirect influence of associated industries. These observations will be integrated into the report.
Cell Therapy Market Trends and Drivers:
The escalating prevalence of several diseases, including cancer and cardiac abnormalities, across the globe and the growing number of clinical studies for cell-based treatments are among the primary factors driving the cell therapy market. Besides this, the introduction of skin rejuvenation and tendon regeneration cures and the development of direct cell reprogramming to replace lost neuronal tissues, on account of neurodegeneration or neurotrauma, are further augmenting the market growth. Moreover, the launch of advanced genomic therapy techniques to treat various conditions, such as heart disease, diabetes, hemophilia, cystic fibrosis, and acquired immune deficiency syndrome (AIDS), and the expanding healthcare industry are also catalyzing the global market. Apart from this, the elevating demand for regenerative medicines to replace organs damaged by illnesses, traumas, or congenital issues is anticipated to propel the cell therapy market over the forecasted period.
Cell Therapy Market 2022-2027 Analysis and Segmentation:
Competitive Landscape:
The competitive landscape of the market has been studied in the report with the detailed profiles of the key players operating in the market.
AlloSource, Anterogen Co. Ltd., Cells for Cells, Holostem Terapie Avanzate S.r.l., JCR Pharmaceuticals, Kolon TissueGene Inc., MEDIPOST, Mesoblast Limited, NuVasive, Stemedica Cell Technologies Inc., Stempeutics Research Pvt. Ltd and Vericel Corporation.
The report has segmented the market on the basis of cell type, therapy type, therapeutic area and end user.
Breakup by Cell Type:
- Stem Cell
- Bone Marrow
- Blood
- Umbilical Cord-Derived
- Adipose-Derived Stem Cell
- Others
- Non-stem Cell
Breakup by Therapy Type:
- Autologous
- Allogeneic
Breakup by Therapeutic Area:
- Malignancies
- Musculoskeletal Disorders
- Autoimmune Disorders
- Dermatology
- Others
Breakup by End User:
- Hospitals and Clinics
- Academic and Research Institutes
Breakup by Region:
- North America: (United States, Canada)
- Asia Pacific: (China, Japan, India, South Korea, Australia, Indonesia, Others)
- Europe: (Germany, France, United Kingdom, Italy, Spain, Russia, Others)
- Latin America: (Brazil, Mexico, Others)
- Middle East and Africa
Key highlights of the report:
• Market Performance (2016-2021)
• Market Outlook (2022- 2027)
• Porter’s Five Forces Analysis
• Market Drivers and Success Factors
• SWOT Analysis
• Value Chain
• Comprehensive Mapping of the Competitive Landscape
If you need specific information that is not currently within the scope of the report, we can provide it to you as a part of the customization.
Contact Us:
IMARC Services Private Limited.
30 N Gould St Ste R
Sheridan, WY 82801 USA – Wyoming
Email: [email protected]
Tel No:(D) +91 120 433 0800
Americas:- +1 631 791 1145 | Africa and Europe :- +44-702-409-7331 | Asia: +91-120-433-0800, +91-120-433-0800
About Us:
IMARC Group is a leading market research company that offers management strategy and market research worldwide. We partner with clients in all sectors and regions to identify their highest-value opportunities, address their most critical challenges, and transform their businesses.
IMARC’s information products include major market, scientific, economic and technological developments for business leaders in pharmaceutical, industrial, and high technology organizations. Market forecasts and industry analysis for biotechnology, advanced materials, pharmaceuticals, food and beverage, travel and tourism, nanotechnology and novel processing methods are at the top of the company’s expertise.